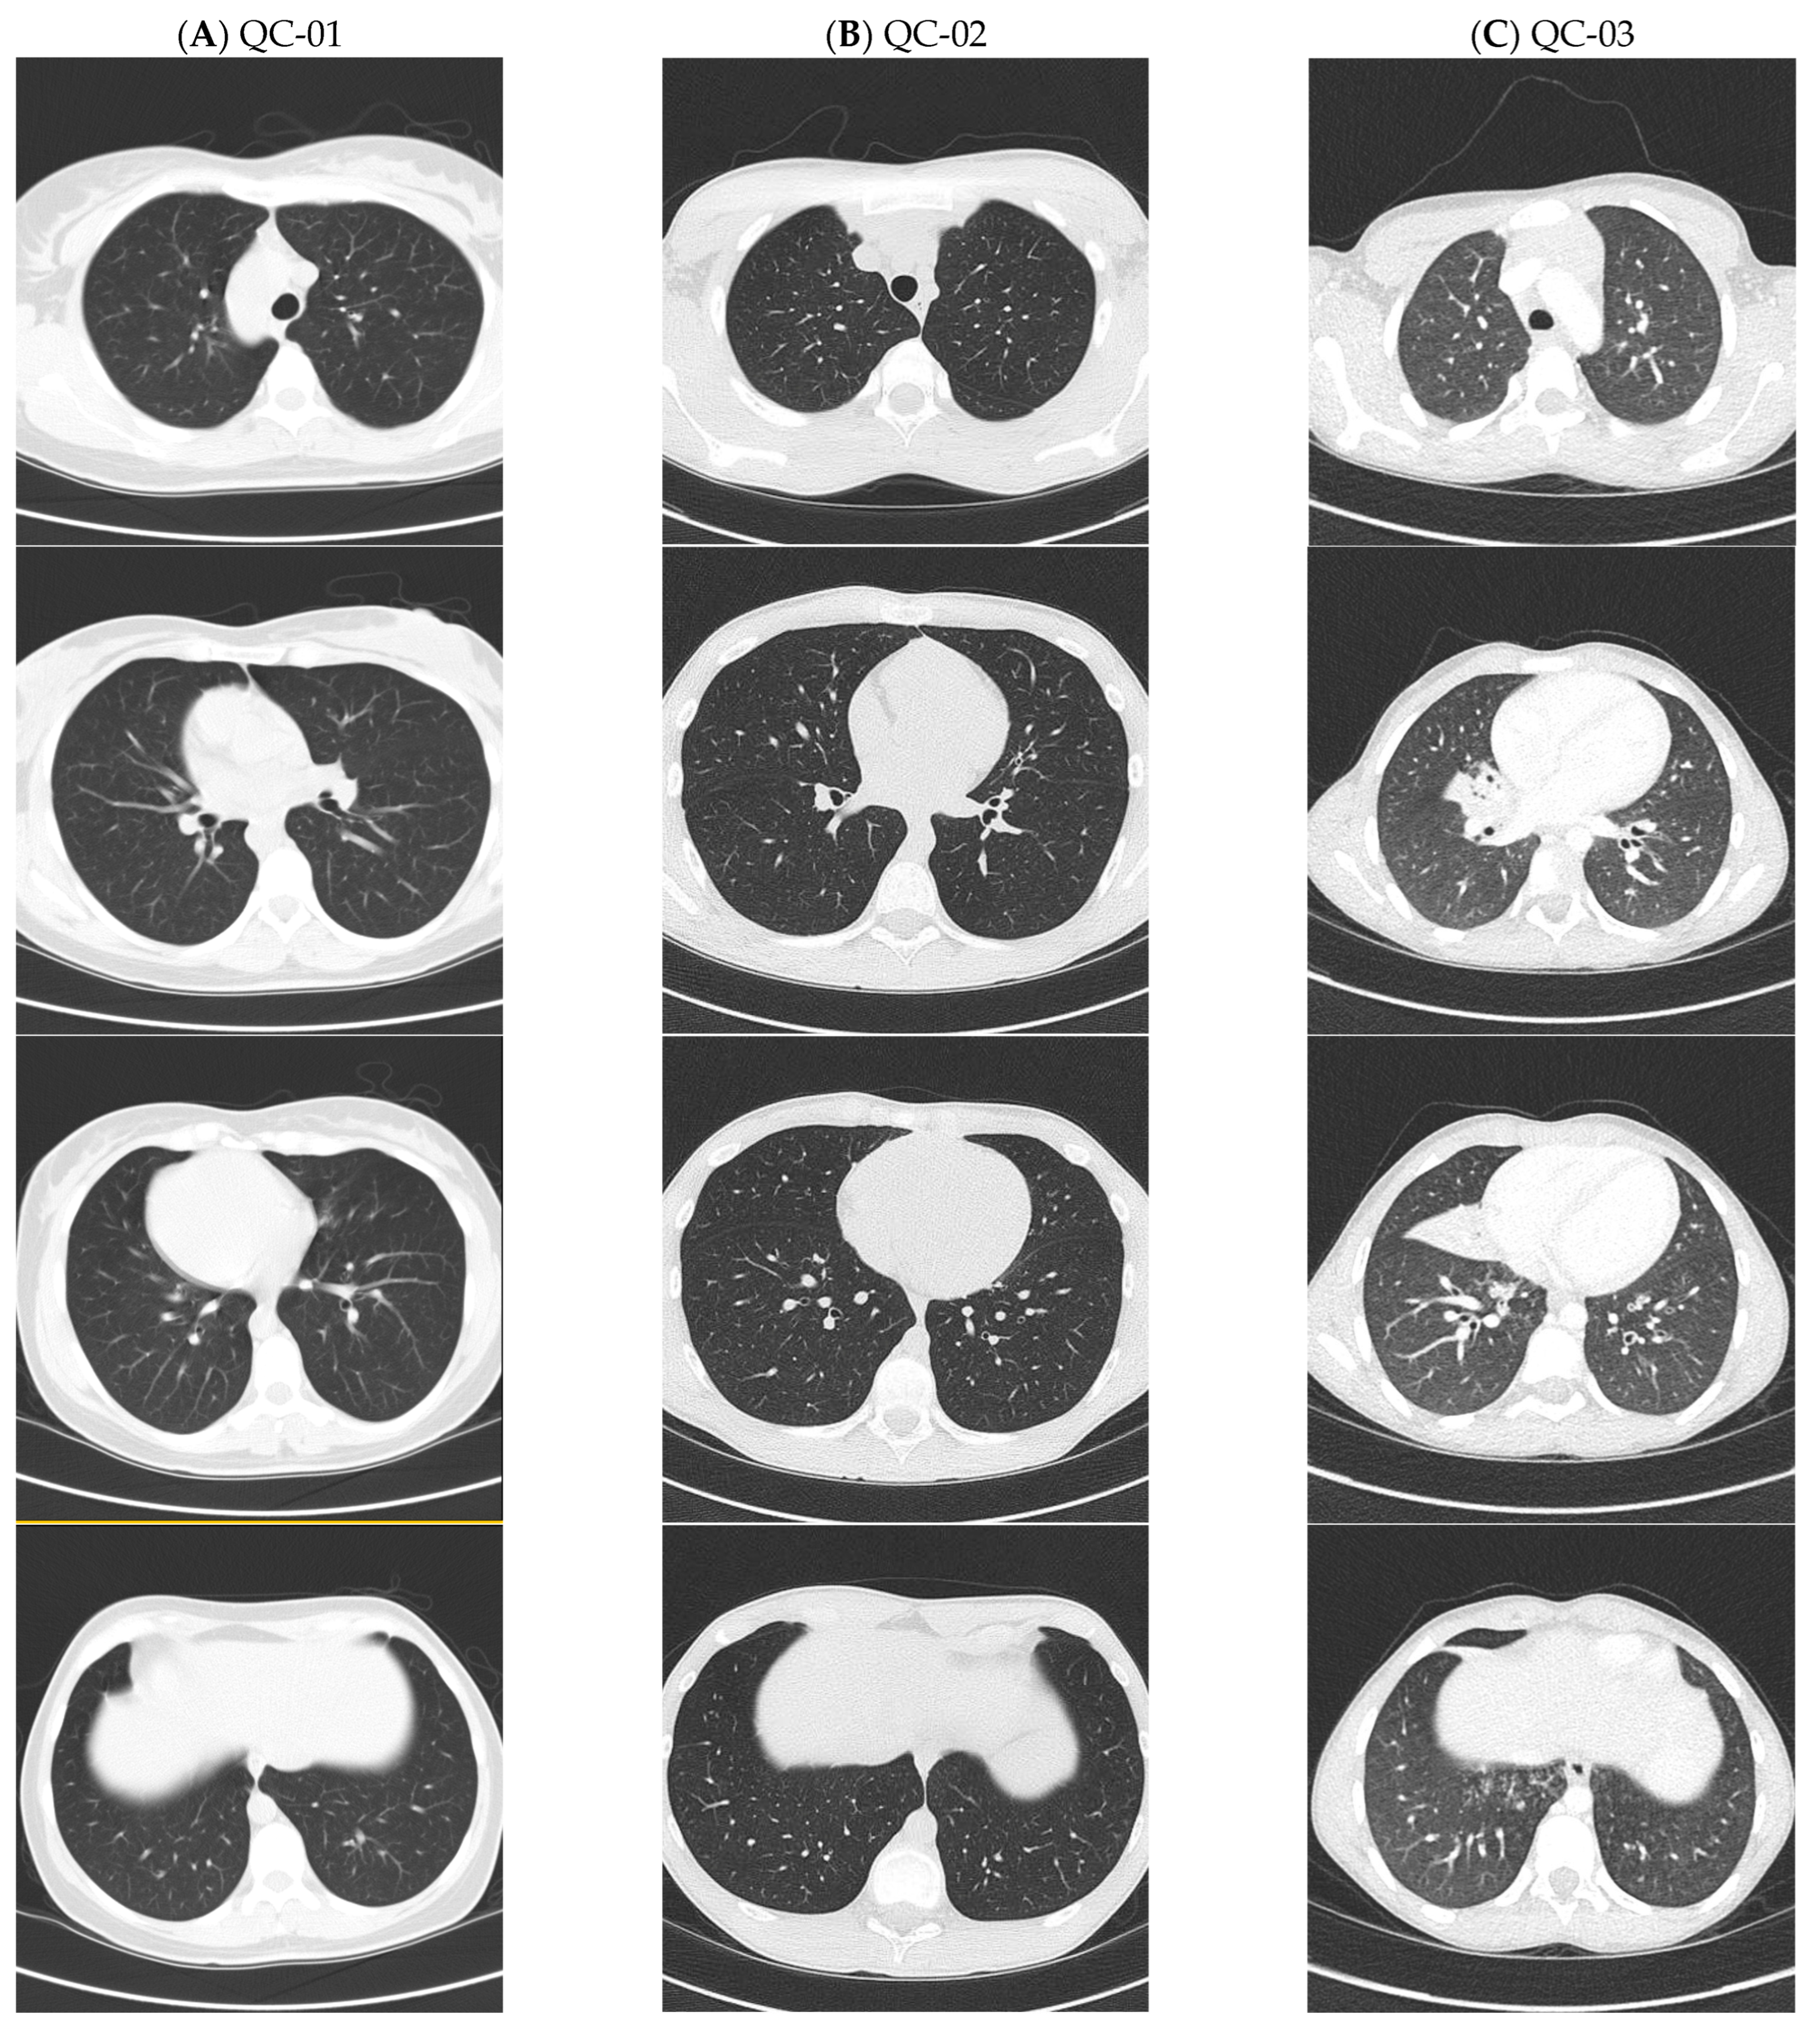
Cells 14 01460 g001

ODAD4-Related Primary Ciliary Dyskinesia: Report of Five Cases and a Founder Variant in Quebec
Abstract
1. Introduction
2. Materials and Methods
2.1. Subjects
2.2. Diagnostic Testing and Genetic Analysis
2.3. Nasal Epithelial Cell Analysis
2.4. In Vivo Mucociliary Clearance Measurement (MCC)
2.5. Analysis of a Quebec Founder Variant
3. Results
4. Discussion
5. Conclusions
Supplementary Materials
Author Contributions
Funding
Institutional Review Board Statement
Informed Consent Statement
Data Availability Statement
Acknowledgments
Conflicts of Interest
References
- Ewen, R.; Pink, I.; Sutharsan, S.; Aries, S.P.; Grunewaldt, A.; Shoemark, A.; Sommerwerck, U.; Staar, B.O.; Wege, S.; Mertsch, P.; et al. Primary Ciliary Dyskinesia in Adult Bronchiectasis: Data from the German Bronchiectasis Registry PROGNOSIS. Chest 2024, 166, 938–950. [Google Scholar] [CrossRef]
- Raidt, J.; Loges, N.T.; Olbrich, H.; Wallmeier, J.; Pennekamp, P.; Omran, H. Primary ciliary dyskinesia. Presse Med. 2023, 52, 104171. [Google Scholar] [CrossRef] [PubMed]
- Raidt, J.; Riepenhausen, S.; Pennekamp, P.; Olbrich, H.; Amirav, I.; Athanazio, R.A.; Aviram, M.; Balinotti, J.E.; Bar-On, O.; Bode, S.F.N.; et al. Analyses of 1236 genotyped primary ciliary dyskinesia individuals identify regional clusters of distinct DNA variants and significant genotype-phenotype correlations. Eur. Respir. J. 2024, 64, 2301769. [Google Scholar] [CrossRef]
- Goutaki, M.; Meier, A.B.; Halbeisen, F.S.; Lucas, J.S.; Dell, S.D.; Maurer, E.; Casaulta, C.; Jurca, M.; Spycher, B.D.; Kuehni, C.E. Clinical manifestations in primary ciliary dyskinesia: Systematic review and meta-analysis. Eur. Respir. J. 2016, 48, 1081–1095. [Google Scholar] [CrossRef] [PubMed]
- Lucas, J.S.; Davis, S.D.; Omran, H.; Shoemark, A. Primary ciliary dyskinesia in the genomics age. Lancet Respir. Med. 2020, 8, 202–216. [Google Scholar] [CrossRef] [PubMed]
- Mullowney, T.; Manson, D.; Kim, R.; Stephens, D.; Shah, V.; Dell, S. Primary ciliary dyskinesia and neonatal respiratory distress. Pediatrics 2014, 134, 1160–1166. [Google Scholar] [CrossRef]
- Niwa, Y.; Somiya, K.; Michelson, A.M.; Puget, K. Effect of liposomal-encapsulated superoxide dismutase on active oxygen-related human disorders. A preliminary study. Free Radic. Res Commun. 1985, 1, 137–153. [Google Scholar] [CrossRef]
- Petrarca, L.; Guida, V.; Nenna, R.; De Luca, A.; Goldoni, M.; Bernardini, L.; Conti, M.G.; Cimino, G.; Mancino, E.; Masuelli, L.; et al. Genotype-Phenotype Correlation in a Group of Italian Patients With Primary Ciliary Dyskinesia. Pediatr. Pulmonol. 2025, 60, e71057. [Google Scholar] [CrossRef]
- Jackson, C.L.; Behan, L.; Collins, S.A.; Goggin, P.M.; Adam, E.C.; Coles, J.L.; Evans, H.J.; Harris, A.; Lackie, P.; Packham, S.; et al. Accuracy of diagnostic testing in primary ciliary dyskinesia. Eur. Respir. J. 2016, 47, 837–848. [Google Scholar] [CrossRef]
- Shapiro, A.J.; Davis, S.D.; Polineni, D.; Manion, M.; Rosenfeld, M.; Dell, S.D.; Chilvers, M.A.; Ferkol, T.W.; Zariwala, M.A.; Sagel, S.D.; et al. Diagnosis of Primary Ciliary Dyskinesia. An Official American Thoracic Society Clinical Practice Guideline. Am. J. Respir. Crit. Care Med. 2018, 197, e24–e39. [Google Scholar] [CrossRef]
- Lucas, J.S.; Barbato, A.; Collins, S.A.; Goutaki, M.; Behan, L.; Caudri, D.; Dell, S.; Eber, E.; Escudier, E.; Hirst, R.A.; et al. European Respiratory Society guidelines for the diagnosis of primary ciliary dyskinesia. Eur. Respir. J. 2017, 49, 1601090. [Google Scholar] [CrossRef]
- Rubbo, B.; Lucas, J.S. Clinical care for primary ciliary dyskinesia: Current challenges and future directions. Eur. Respir. Rev. 2017, 26, 170023. [Google Scholar] [CrossRef]
- Keicho, N.; Morimoto, K.; Hijikata, M. The challenge of diagnosing primary ciliary dyskinesia: A commentary on various causative genes and their pathogenic variants. J. Hum. Genet. 2023, 68, 571–575. [Google Scholar] [CrossRef]
- Wheway, G.; Thomas, N.S.; Carroll, M.; Coles, J.; Doherty, R.; Goggin, P.; Green, B.; Harris, A.; Hunt, D.; Jackson, C.L.; et al. Whole genome sequencing in the diagnosis of primary ciliary dyskinesia. BMC Med. Genom. 2021, 14, 234. [Google Scholar] [CrossRef] [PubMed]
- Cant, E.; Shoemark, A.; Chalmers, J.D. Primary Ciliary Dyskinesia: Integrating Genetics into Clinical Practice. Curr. Pulmonol. Rep. 2024, 13, 57–66. [Google Scholar] [CrossRef]
- Fassad, M.R.; Patel, M.P.; Shoemark, A.; Cullup, T.; Hayward, J.; Dixon, M.; Rogers, A.V.; Ollosson, S.; Jackson, C.; Goggin, P.; et al. Clinical utility of NGS diagnosis and disease stratification in a multiethnic primary ciliary dyskinesia cohort. J. Med. Genet. 2020, 57, 322–330. [Google Scholar] [CrossRef] [PubMed]
- Lei, C.; Wang, R.; Yang, D.; Guo, T.; Luo, H. Clinical phenotypes of primary ciliary dyskinesia. Zhong Nan Da Xue Xue Bao Yi Xue Ban 2022, 47, 116–122. [Google Scholar] [CrossRef]
- Guichard, C.; Harricane, M.C.; Lafitte, J.J.; Godard, P.; Zaegel, M.; Tack, V.; Lalau, G.; Bouvagnet, P. Axonemal dynein intermediate-chain gene (DNAI1) mutations result in situs inversus and primary ciliary dyskinesia (Kartagener syndrome). Am. J. Hum. Genet. 2001, 68, 1030–1035. [Google Scholar] [CrossRef]
- Karakoc, E.; Hjeij, R.; Kaya, Z.B.; Emiralioglu, N.; Ademhan Tural, D.; Atilla, P.; Ozcelik, U.; Omran, H. Diagnostic Role of Immunofluorescence Analysis in Primary Ciliary Dyskinesia-Suspected Individuals. J. Clin. Med. 2025, 14, 1941. [Google Scholar] [CrossRef]
- Loges, N.T.; Antony, D.; Maver, A.; Deardorff, M.A.; Gulec, E.Y.; Gezdirici, A.; Nothe-Menchen, T.; Hoben, I.M.; Jelten, L.; Frank, D.; et al. Recessive DNAH9 Loss-of-Function Mutations Cause Laterality Defects and Subtle Respiratory Ciliary-Beating Defects. Am. J. Hum. Genet. 2018, 103, 995–1008. [Google Scholar] [CrossRef]
- Tsybul’kin, E.K.; Liubimenko, V.A.; Tsyrkin, S.A. Specific features of postoperative infusion therapy depending on kidney function in newborn infants with developmental defects. Vestn. Khirurgii Im. II Grek. 1987, 138, 82–86. [Google Scholar]
- Onoufriadis, A.; Paff, T.; Antony, D.; Shoemark, A.; Micha, D.; Kuyt, B.; Schmidts, M.; Petridi, S.; Dankert-Roelse, J.E.; Haarman, E.G.; et al. Splice-site mutations in the axonemal outer dynein arm docking complex gene CCDC114 cause primary ciliary dyskinesia. Am. J. Hum. Genet. 2013, 92, 88–98. [Google Scholar] [CrossRef]
- Takada, S.; Wilkerson, C.G.; Wakabayashi, K.; Kamiya, R.; Witman, G.B. The outer dynein arm-docking complex: Composition and characterization of a subunit (oda1) necessary for outer arm assembly. Mol. Biol. Cell 2002, 13, 1015–1029. [Google Scholar] [CrossRef] [PubMed]
- Wallmeier, J.; Shiratori, H.; Dougherty, G.W.; Edelbusch, C.; Hjeij, R.; Loges, N.T.; Menchen, T.; Olbrich, H.; Pennekamp, P.; Raidt, J.; et al. TTC25 Deficiency Results in Defects of the Outer Dynein Arm Docking Machinery and Primary Ciliary Dyskinesia with Left-Right Body Asymmetry Randomization. Am. J. Hum. Genet. 2016, 99, 460–469. [Google Scholar] [CrossRef]
- Backman, K.; Mears, W.E.; Waheeb, A.; Beaulieu Bergeron, M.; McClintock, J.; de Nanassy, J.; Reisman, J.; Osmond, M.; Hartley, T.; Mears, A.J.; et al. A splice site and copy number variant responsible for TTC25-related primary ciliary dyskinesia. Eur. J. Med. Genet. 2021, 64, 104193. [Google Scholar] [CrossRef]
- Emiralioglu, N.; Taskiran, E.Z.; Kosukcu, C.; Bilgic, E.; Atilla, P.; Kaya, B.; Gunaydin, O.; Yuzbasioglu, A.; Tugcu, G.D.; Ademhan, D.; et al. Genotype and phenotype evaluation of patients with primary ciliary dyskinesia: First results from Turkey. Pediatr. Pulmonol. 2020, 55, 383–393. [Google Scholar] [CrossRef]
- Mani, R.; Belkacem, S.; Soua, Z.; Chantot, S.; Montantin, G.; Tissier, S.; Copin, B.; Bouguila, J.; Rive Le Gouard, N.; Boughamoura, L.; et al. Primary ciliary dyskinesia gene contribution in Tunisia: Identification of a major Mediterranean allele. Hum. Mutat. 2020, 41, 115–121. [Google Scholar] [CrossRef]
- Yiallouros, P.K.; Kouis, P.; Kyriacou, K.; Evriviadou, A.; Anagnostopoulou, P.; Matthaiou, A.; Tsiolakis, I.; Pirpa, P.; Michailidou, K.; Potamiti, L.; et al. Implementation of multigene panel NGS diagnosis in the national primary ciliary dyskinesia cohort of Cyprus: An island with a high disease prevalence. Hum. Mutat. 2021, 42, e62–e77. [Google Scholar] [CrossRef]
- Zlotina, A.; Barashkova, S.; Zhuk, S.; Skitchenko, R.; Usoltsev, D.; Sokolnikova, P.; Artomov, M.; Alekseenko, S.; Simanova, T.; Goloborodko, M.; et al. Characterization of pathogenic genetic variants in Russian patients with primary ciliary dyskinesia using gene panel sequencing and transcript analysis. Orphanet J. Rare Dis. 2024, 19, 310. [Google Scholar] [CrossRef]
- Shapiro, A.J.; Dell, S.D.; Gaston, B.; O’Connor, M.; Marozkina, N.; Manion, M.; Hazucha, M.J.; Leigh, M.W. Nasal Nitric Oxide Measurement in Primary Ciliary Dyskinesia. A Technical Paper on Standardized Testing Protocols. Ann. Am. Thorac. Soc. 2020, 17, e1–e12. [Google Scholar] [CrossRef]
- Shoemark, A.; Boon, M.; Brochhausen, C.; Bukowy-Bieryllo, Z.; De Santi, M.M.; Goggin, P.; Griffin, P.; Hegele, R.G.; Hirst, R.A.; Leigh, M.W.; et al. International consensus guideline for reporting transmission electron microscopy results in the diagnosis of primary ciliary dyskinesia (BEAT PCD TEM Criteria). Eur. Respir. J. 2020, 55, 1900725. [Google Scholar] [CrossRef] [PubMed]
- Smith, A.J.; Bustamante-Marin, X.M.; Yin, W.; Sears, P.R.; Herring, L.E.; Dicheva, N.N.; Lopez-Giraldez, F.; Mane, S.; Tarran, R.; Leigh, M.W.; et al. The role of SPAG1 in the assembly of axonemal dyneins in human airway epithelia. J. Cell Sci. 2022, 135, jcs259512. [Google Scholar] [CrossRef] [PubMed]
- Richards, S.; Aziz, N.; Bale, S.; Bick, D.; Das, S.; Gastier-Foster, J.; Grody, W.W.; Hegde, M.; Lyon, E.; Spector, E.; et al. Standards and guidelines for the interpretation of sequence variants: A joint consensus recommendation of the American College of Medical Genetics and Genomics and the Association for Molecular Pathology. Genet. Med. 2015, 17, 405–424. [Google Scholar] [CrossRef] [PubMed]
- McCravy, M.S.; Quinney, N.L.; Cholon, D.M.; Boyles, S.E.; Jensen, T.J.; Aleksandrov, A.A.; Donaldson, S.H.; Noone, P.G.; Gentzsch, M. Personalised medicine for non-classic cystic fibrosis resulting from rare CFTR mutations. Eur. Respir. J. 2020, 56, 2000062. [Google Scholar] [CrossRef]
- Knowles, M.R.; Ostrowski, L.E.; Leigh, M.W.; Sears, P.R.; Davis, S.D.; Wolf, W.E.; Hazucha, M.J.; Carson, J.L.; Olivier, K.N.; Sagel, S.D.; et al. Mutations in RSPH1 cause primary ciliary dyskinesia with a unique clinical and ciliary phenotype. Am. J. Respir. Crit. Care Med. 2014, 189, 707–717. [Google Scholar] [CrossRef]
- Bennett, W.D.; Wu, J.; Fuller, F.; Balcazar, J.R.; Zeman, K.L.; Duckworth, H.; Donn, K.H.; O’Riordan, T.G.; Boucher, R.C.; Donaldson, S.H. Duration of action of hypertonic saline on mucociliary clearance in the normal lung. J. Appl. Physiol. 2015, 118, 1483–1490. [Google Scholar] [CrossRef]
- McClelland, P.; Femerling, G.; Laflamme, R.; Mejia-Garcia, A.; Dehkordi, M.S.; Xiao, H.; Diaz-Papkovich, A.; Pelletier, J.; Grenier, J.-C.; Lo, K.S.; et al. A multi-ancestry genetic reference for the Quebec population. medRxiv 2025. [Google Scholar] [CrossRef]
- Zhang, B.C.; Biddanda, A.; Gunnarsson, A.F.; Cooper, F.; Palamara, P.F. Biobank-scale inference of ancestral recombination graphs enables genealogical analysis of complex traits. Nat. Genet. 2023, 55, 768–776. [Google Scholar] [CrossRef]
- Garcia, A.M.; Diaz-Papkovich, A.; Sillon, G.; D’Agostino, D.; Chong, A.-L.; Chong, G.; Lo, K.S.; Baret, L.; Hamel, N.; Chapdelaine, V.; et al. Using the ancestral recombination graph to study the history of rare variants in founder populations. bioRxiv 2025. [Google Scholar] [CrossRef]
- Nelson, D.; Moreau, C.; de Vriendt, M.; Zeng, Y.; Preuss, C.; Vezina, H.; Milot, E.; Andelfinger, G.; Labuda, D.; Gravel, S. Inferring Transmission Histories of Rare Alleles in Population-Scale Genealogies. Am. J. Hum. Genet. 2018, 103, 893–906. [Google Scholar] [CrossRef]
- Leigh, M.W.; Hazucha, M.J.; Chawla, K.K.; Baker, B.R.; Shapiro, A.J.; Brown, D.E.; Lavange, L.M.; Horton, B.J.; Qaqish, B.; Carson, J.L.; et al. Standardizing nasal nitric oxide measurement as a test for primary ciliary dyskinesia. Ann. Am. Thorac. Soc. 2013, 10, 574–581. [Google Scholar] [CrossRef]
- O’Callaghan, C.; Rutman, A.; Williams, G.M.; Hirst, R.A. Inner dynein arm defects causing primary ciliary dyskinesia: Repeat testing required. Eur. Respir. J. 2011, 38, 603–607. [Google Scholar] [CrossRef] [PubMed]
- Hjeij, R.; Aprea, I.; Poeta, M.; Nothe-Menchen, T.; Bracht, D.; Raidt, J.; Honecker, B.I.; Dougherty, G.W.; Olbrich, H.; Schwartz, O.; et al. Pathogenic variants in CLXN encoding the outer dynein arm docking-associated calcium-binding protein calaxin cause primary ciliary dyskinesia. Genet. Med. 2023, 25, 100798. [Google Scholar] [CrossRef] [PubMed]
- Hjeij, R.; Onoufriadis, A.; Watson, C.M.; Slagle, C.E.; Klena, N.T.; Dougherty, G.W.; Kurkowiak, M.; Loges, N.T.; Diggle, C.P.; Morante, N.F.; et al. CCDC151 mutations cause primary ciliary dyskinesia by disruption of the outer dynein arm docking complex formation. Am. J. Hum. Genet. 2014, 95, 257–274. [Google Scholar] [CrossRef] [PubMed]
- Kos, R.; Israels, J.; van Gogh, C.D.L.; Altenburg, J.; Diepenhorst, S.; Paff, T.; Boon, E.M.J.; Micha, D.; Pals, G.; Neerincx, A.H.; et al. Primary ciliary dyskinesia in Volendam: Diagnostic and phenotypic features in patients with a CCDC114 mutation. Am. J. Med. Genet. C Semin. Med. Genet. 2022, 190, 89–101. [Google Scholar] [CrossRef]
- Shoemark, A.; Rubbo, B.; Legendre, M.; Fassad, M.R.; Haarman, E.G.; Best, S.; Bon, I.C.M.; Brandsma, J.; Burgel, P.R.; Carlsson, G.; et al. Topological data analysis reveals genotype-phenotype relationships in primary ciliary dyskinesia. Eur. Respir. J. 2021, 58, 2002359. [Google Scholar] [CrossRef]
- Horani, A.; Gupta, D.K.; Xu, J.; Xu, H.; Carmen Puga-Molina, L.D.; Santi, C.M.; Ramagiri, S.; Brennan, S.K.; Pan, J.; Koenitzer, J.R.; et al. The effect of Dnaaf5 gene dosage on primary ciliary dyskinesia phenotypes. JCI Insight 2023, 8, e168836. [Google Scholar] [CrossRef]
- Shoemark, A.; Moya, E.; Hirst, R.A.; Patel, M.P.; Robson, E.A.; Hayward, J.; Scully, J.; Fassad, M.R.; Lamb, W.; Schmidts, M.; et al. High prevalence of CCDC103 p.His154Pro mutation causing primary ciliary dyskinesia disrupts protein oligomerisation and is associated with normal diagnostic investigations. Thorax 2018, 73, 157–166. [Google Scholar] [CrossRef]
- Butnariu, L.I.; Tarca, E.; Cojocaru, E.; Rusu, C.; Moisa, S.M.; Leon Constantin, M.M.; Gorduza, E.V.; Trandafir, L.M. Genetic Modifying Factors of Cystic Fibrosis Phenotype: A Challenge for Modern Medicine. J. Clin. Med. 2021, 10, 5821. [Google Scholar] [CrossRef]
- Middleton, P.G.; Mall, M.A.; Drevinek, P.; Lands, L.C.; McKone, E.F.; Polineni, D.; Ramsey, B.W.; Taylor-Cousar, J.L.; Tullis, E.; Vermeulen, F.; et al. Elexacaftor-Tezacaftor-Ivacaftor for Cystic Fibrosis with a Single Phe508del Allele. N. Engl. J. Med. 2019, 381, 1809–1819. [Google Scholar] [CrossRef]
- Ramsey, B.W.; Davies, J.; McElvaney, N.G.; Tullis, E.; Bell, S.C.; Drevinek, P.; Griese, M.; McKone, E.F.; Wainwright, C.E.; Konstan, M.W.; et al. A CFTR potentiator in patients with cystic fibrosis and the G551D mutation. N. Engl. J. Med. 2011, 365, 1663–1672. [Google Scholar] [CrossRef]
- Taylor-Cousar, J.L.; Munck, A.; McKone, E.F.; van der Ent, C.K.; Moeller, A.; Simard, C.; Wang, L.T.; Ingenito, E.P.; McKee, C.; Lu, Y.; et al. Tezacaftor-Ivacaftor in Patients with Cystic Fibrosis Homozygous for Phe508del. N. Engl. J. Med. 2017, 377, 2013–2023. [Google Scholar] [CrossRef]
- Wainwright, C.E.; Elborn, J.S.; Ramsey, B.W.; Marigowda, G.; Huang, X.; Cipolli, M.; Colombo, C.; Davies, J.C.; De Boeck, K.; Flume, P.A.; et al. Lumacaftor-Ivacaftor in Patients with Cystic Fibrosis Homozygous for Phe508del CFTR. N. Engl. J. Med. 2015, 373, 220–231. [Google Scholar] [CrossRef]
- Anderson-Trocme, L.; Nelson, D.; Zabad, S.; Diaz-Papkovich, A.; Kryukov, I.; Baya, N.; Touvier, M.; Jeffery, B.; Dina, C.; Vezina, H.; et al. On the genes, genealogies, and geographies of Quebec. Science 2023, 380, 849–855. [Google Scholar] [CrossRef]

| Patient ID | Gender | Age at Diagnosis (Years) | Ethnicity | ODAD4 (TTC25) Variants | nNO (nL/Min) | TEM | HSVA |
|---|---|---|---|---|---|---|---|
| QC-01 | F | 41 | White, French-Canadian | c.245delA, p.(Lys82Argfs*29)—Path, HOM | 10, 12 | Absent ODA 92% of sections | No activity |
| QC-02 | M | 11 | White, French-Canadian | c.245delA, p.(Lys82Argfs*29)—Path, HOM | 13, 6, 21 | Absent ODA 85% of sections | No activity |
| QC-03 | M | 3 | White, French-Canadian | c.245delA, p.(Lys82Argfs*29)—Path, HOM | 6 * | Absent ODA 100% of sections | ND |
| NC-01 | M | 3 | White | c.245delA, p.(Lys82Argfs*29)—Path; c.731delC, p.(Pro244Argfs*11)—Path, Compd Het | 15 | Absent ODA 100% of sections | ND |
| NC-02 | M | 10 | Hispanic | c.100C>T, p.(Gln34*)–Path; c.1145 + 1G>A, p.(Splice donor)—Path, Compd Het | 26 | Absent ODA 91% of sections | ND |
| Patient | NRDS | Chronic Rhino-Sinusitis | ROM | Chronic Wet Cough | Recurrent Pneumonia | Bronchiectasis on CT, Lobe Affected (Age Detected) | Situs | FEV1 (%) | Sputum Organisms |
|---|---|---|---|---|---|---|---|---|---|
| QC-01 | No | Yes | Yes | Yes | No | No (38) | SIT | 95 | OP flora, MBKub |
| QC-02 | Yes | Yes | Yes | Yes | No | No (14) | SS | 107 | StAur, MCat, StrPne, PsA (eradicated) |
| QC-03 | Yes | No | Yes | Yes | Yes | Yes—RML (8) | SA | 106 | StAur, StrPyo MCat, HFlu |
| NC-01 | No | Yes | Yes | Yes | Yes | Yes—RLL (4) | SIT | 89 | StAur, Hflu, MCat, StrPne, PsA |
| NC-02 | No | Yes | No | Yes | No | CT not done | SIT | 100 | PsA |
| CARTaGENE | |||||||
|---|---|---|---|---|---|---|---|
| GRCh38 Genomic Location | TMRCA (Generations) | GnomAD NFE | WGS |
ARG Imputation |
TOPMED Imputation |
Bas Saint- Laurent | Côte du Sud |
| ODAD4 (TTC25): chr17-41935345-TA-T | 11.4 | 1/5840 | 3 | 59 | 67 | 1/111 | 1/143 |
Disclaimer/Publisher’s Note: The statements, opinions and data contained in all publications are solely those of the individual author(s) and contributor(s) and not of MDPI and/or the editor(s). MDPI and/or the editor(s) disclaim responsibility for any injury to people or property resulting from any ideas, methods, instructions or products referred to in the content. |
© 2025 by the authors. Licensee MDPI, Basel, Switzerland. This article is an open access article distributed under the terms and conditions of the Creative Commons Attribution (CC BY) license (https://creativecommons.org/licenses/by/4.0/).
Share and Cite
Bourassa, M.-H.; Sillon, G.; Ding, S.; Chioccioli, M.; Lek, M.; Ma, K.; Mejia-Garcia, A.; Gravel, S.; Vinh, D.C.; Knowles, M.R.; et al. ODAD4-Related Primary Ciliary Dyskinesia: Report of Five Cases and a Founder Variant in Quebec. Cells 2025, 14, 1460. https://doi.org/10.3390/cells14181460
Bourassa M-H, Sillon G, Ding S, Chioccioli M, Lek M, Ma K, Mejia-Garcia A, Gravel S, Vinh DC, Knowles MR, et al. ODAD4-Related Primary Ciliary Dyskinesia: Report of Five Cases and a Founder Variant in Quebec. Cells. 2025; 14(18):1460. https://doi.org/10.3390/cells14181460
Chicago/Turabian StyleBourassa, Marie-Hélène, Guillaume Sillon, Shuizi Ding, Maurizio Chioccioli, Monkol Lek, Kaiyue Ma, Alejandro Mejia-Garcia, Simon Gravel, Donald C. Vinh, Michael R. Knowles, and et al. 2025. "ODAD4-Related Primary Ciliary Dyskinesia: Report of Five Cases and a Founder Variant in Quebec" Cells 14, no. 18: 1460. https://doi.org/10.3390/cells14181460
APA StyleBourassa, M.-H., Sillon, G., Ding, S., Chioccioli, M., Lek, M., Ma, K., Mejia-Garcia, A., Gravel, S., Vinh, D. C., Knowles, M. R., Leigh, M. W., Davis, S. D., Ferkol, T., Olivier, K. N., Schecterman, E. N., Yin, W., Sears, P. R., Gentzsch, M., Boyles, S. E., ... Shapiro, A. J. (2025). ODAD4-Related Primary Ciliary Dyskinesia: Report of Five Cases and a Founder Variant in Quebec. Cells, 14(18), 1460. https://doi.org/10.3390/cells14181460

